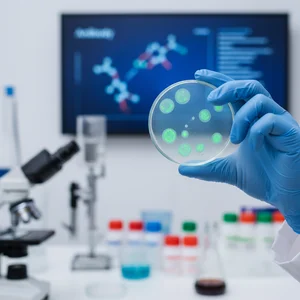
Immunologi

Upptäck specialiteterna inom området Hälsa
Våra Hälsa-experter är kvalificerade yrkespersoner som är tillgängliga för att svara på alla dina frågor. Få spetskompetens och personlig rådgivning.
Snabba svar
4.9/5
Våra specialiteter
Välj ditt expertområde
A
Akutsjukvård
UpptäckA
Allmänmedicin
UpptäckA
Alternativ medicin
UpptäckA
Arbetsmedicin
UpptäckA
Ashtangayoga
UpptäckA
Avancerad yoga
UpptäckB
Barnyoga
UpptäckB
Beroendemedicin
UpptäckB
Bikramyoga
UpptäckD
Dermatologi
UpptäckE
Endokrinologi
UpptäckF
Företagsyoga
UpptäckG
Gastroenterologi
UpptäckG
Geriatrik
UpptäckG
Gravidyoga
UpptäckG
Gynekologi
UpptäckH
Hathayoga
UpptäckH
Hematologi
UpptäckI
Idrottsmedicin
UpptäckI
Immunologi
UpptäckI
Iyengaryoga
UpptäckK
Kardiologi
UpptäckK
Klinisk psykologi
UpptäckK
Kostrådgivning
UpptäckK
Kundaliniyoga
UpptäckL
Lungmedicin
UpptäckN
Nefrologi
UpptäckN
Neurologi
UpptäckO
Oftalmologi
UpptäckO
Onkologi
UpptäckO
Onlineyoga
UpptäckÖ
Öron-, näs- och halssjukdomar
UpptäckO
Ortopedi
UpptäckP
Pediatrik
UpptäckP
Postnatal yoga
UpptäckP
Psykiatri
UpptäckR
Radiologi
UpptäckR
Restorativ yoga
UpptäckR
Reumatologi
UpptäckT
Terapeutisk yoga
UpptäckT
Tropikmedicin
UpptäckU
Urologi
UpptäckV
Vinyasayoga
UpptäckY
Yoga för idrottare
UpptäckY
Yoga för nybörjare
UpptäckY
Yoga för seniorer
UpptäckY
Yoga för stresshantering
UpptäckY
Yogakurser
UpptäckY
Yoga och meditation
UpptäckHur fungerar det?
Få ett expertsvar i 3 enkla steg
1
Ställ din fråga
Beskriv ditt problem i detalj. Lägg till dokument om det behövs.
2
Expert tilldelad
Vårt system hittar den mest kvalificerade experten för din fråga.
3
Få ditt svar
Få ett detaljerat och professionellt svar på några minuter.